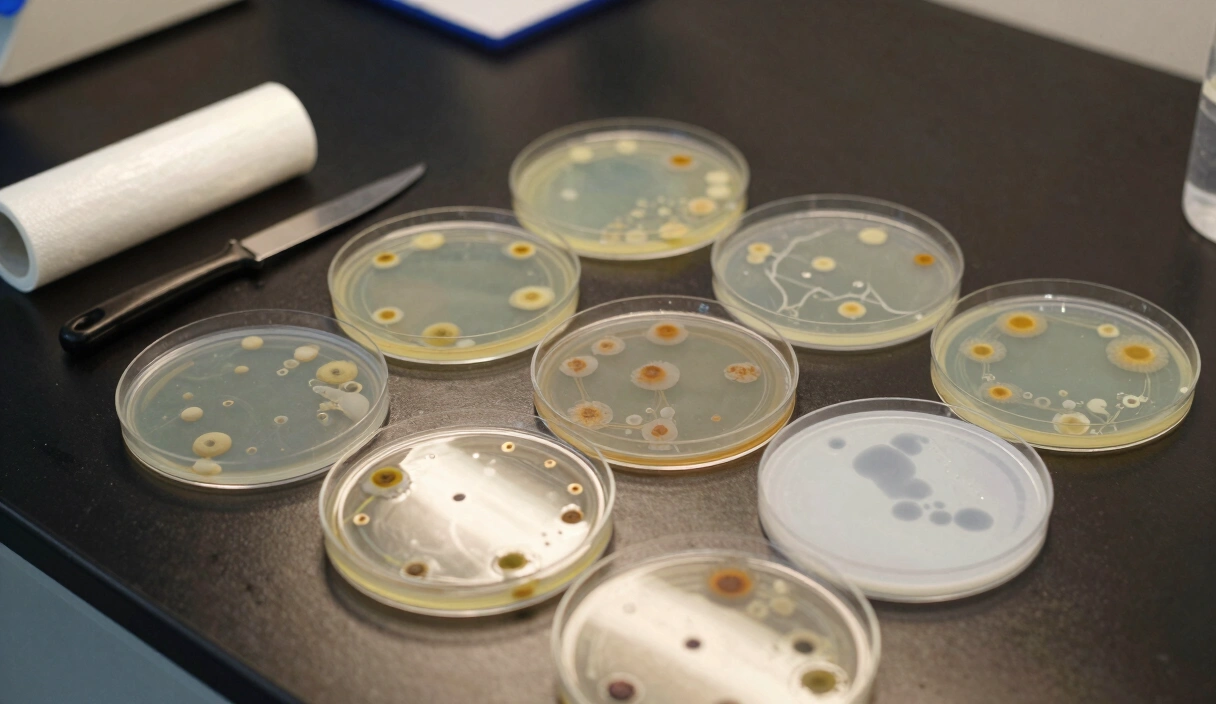
MEA vs. PDA: The Professional Laboratory Guide to Mushroom Agar Recipes

The Monotub Masterclass: Engineering Fresh Air Exchange for High-Yield Grows
Everything about monotub design — hole placement, polyfill density, and the convection physics that make or break your first bulk grow.
Contents
Why do some monotubs produce massive flushes with zero manual fanning while yours needs misting three times a day? The answer has nothing to do with genetics or substrate quality. It comes down to physics – specifically, how Carbon Dioxide (CO2) pools on your substrate surface like an invisible blanket, and whether your monotub hole placement creates enough passive convection to sweep it away.
A monotub is not a plastic bin with holes. It is a self-regulating bioreactor that balances humidity retention against Fresh Air Exchange (FAE) using nothing more than metabolic heat and atmospheric pressure. Get the airflow engineering wrong, and you get fuzzy feet, leggy stems, and a Biological Efficiency (BE) stuck below 60%. Get it right, and the system runs itself for an entire flush cycle. No electronics required.
The Physics of FAE: CO2 Density and Convection
The primary challenge in a closed grow environment is the weight of the air. CO2 is approximately 1.5 times denser than oxygen. As your mycelium breathes, it creates a stagnant, invisible pool of CO2 that settles directly onto the substrate surface.
The “Suffocation” Barrier
In nature, mushrooms grow in open air where wind removes CO2. In a monotub, this CO2 layer acts as a biological “off-switch” for fruiting. To trigger primordia formation, you must break this barrier.
- Thermal Convection: As the mycelium consumes nutrients, it generates metabolic heat. This heat warms the air inside the tub, causing it to expand and rise.
- The Convection Current: By placing holes at the top and bottom of the tub, you create a chimney effect. The warm, stale air exits through the top holes, creating a slight vacuum that pulls fresh, oxygen-rich air in through the bottom holes.
The Evolution of Design: Modified vs. Unmodified
The Monotub has undergone a decade of refinement in underground labs and forums like Shroomery. Today, two competing schools of thought dominate.
1. The Modified Monotub (The “Damion501” Standard)
This design uses six 2-inch holes drilled at specific heights and stuffed with Polyfill or covered with Micropore Tape.
- The Rationale: It offers the highest degree of control. By adjusting the density of the polyfill, you can “dial in” the FAE to match your specific room humidity.
- Best For: Low-humidity environments or species like Oysters that are “O2-hungry.”
2. The Unmodified Monotub (The “Bod” Tek)
Pioneered by the user Bodhisatta, this method uses a standard bin with no holes. Air exchange is managed simply by flipping the lid upside down to create a 1/16th-inch gap.
- The Rationale: Simplicity and cleanliness. It eliminates the need for power tools and makes the tub easier to sanitize between grows.
- Best For: High-humidity environments and growers who prefer a minimalist workflow.
Advanced Monotub Automation & Gear

Spider Farmer Smart Ultrasonic Humidifier (5L)
Automatic humidifier with built-in hygrometer for precise fruiting chamber control.
Check Price on Amazon
KETOTEK Digital Humidity Regulator Socket
Plug-and-play hygrostat sensor for automated humidity management.
Check Price on Amazon
Superior Dung-Loving Mushroom Substrate & Milo Grain 6lb All-in-One Bag
Pre-sterilized all-in-one grow bag with coir, vermiculite, and gypsum formula.
Check Price on Amazon* Affiliate links. Prices last updated July 2, 2026.
Construction Masterclass: Building the ShroomCraft Lab Standard
If you choose the modified route, precision matters. For a standard 54–66 quart clear plastic bin (like the Sterilite Gasket Box), follow this blueprint:
The Tools
Don’t use a standard drill bit; it will crack the plastic. Use a Hole Saw or the Tuna Can Tek: Heat the rim of an empty 2-inch metal can until glowing, then melt through the plastic for a perfectly reinforced, smooth-edged hole.
Picture this: 11 PM, kitchen counter, Sterilite bin in one hand, cordless drill in the other, a spiderweb of cracks radiating from the first hole because I used a spade bit. I drove to Home Depot the next morning for a proper hole saw.
Hole Placement Strategy
- Lower Side Holes (4x): Place two holes on each long side, approximately 4–5 inches from the bottom. These should be just above your finished substrate line. This is where the CO2 will exit.
- Upper End Holes (2x): Place one hole on each short side near the very top, just below the handles. These act as the intake for fresh air.

The Liner Myth: Science vs. Tradition
One of the most debated topics in mycology is the use of a black plastic liner. Beginners often believe the liner prevents Side-Pins by blocking light. This is scientifically incorrect.
The Surface Tension Principle
Side-pins are caused by a micro-climate. As the mycelium consumes the substrate, the block shrinks and pulls away from the walls of the tub. This creates a tiny air gap with 100% humidity—a perfect trigger for pins.
- How the Liner Works: A thin plastic liner (like a heavy-duty trash bag) sticks to the substrate via moisture and surface tension. As the block shrinks, the liner shrinks with it, maintaining a tight seal and eliminating the air gap.
- The Result: By removing the micro-climate at the edges, you force the mycelium to fruit only on the top surface where FAE is managed.
Opening a tub at 6 AM to find 40 side-pins and a bare top surface – after you spent 20 minutes loading the substrate the night before – is the kind of frustration that makes you want to throw the whole bin in the yard. Use a liner. Always.
Dialing In: Reading the Mycelial Signals
A professional grower doesn’t guess; they observe. Your mushrooms will tell you if your FAE engineering is correct.
| Signal | Diagnosis | Technical Fix |
|---|---|---|
| Fuzzy Feet | High CO2 at the base | Loosen the polyfill in the bottom holes. |
| Cracked Caps | Low Humidity | Tighten the polyfill in all holes; check humidifier. |
| Aerial Mycelium | Poor Gas Exchange | Increase FAE; check for stagnant air in the room. |
| Stalled Pins | Evaporation Failure | Increase FAE to stimulate surface evaporation. |
The Evaporation Trigger
Pinning is primarily triggered by Surface Evaporation. If your tub is so sealed that no moisture evaporates, your primordia will never form. You want a very slight, constant movement of air that slowly pulls moisture off the mycelial surface, signaling the fungus that it has reached the “outside world.”
Here is the part that surprised me: my best flush ever – 1.8 lbs from a single 66-quart Sterilite – happened when the room humidity dropped to 55% during a winter cold snap. The increased evaporation gradient at the surface triggered a pin set I have never been able to replicate.
Once your polyfill density holds 90%+ humidity through a full flush without manual misting, the monotub is dialed in – and the next bottleneck becomes substrate chemistry. Get the CVG recipe right with the Ultimate Mushroom Substrate Guide.
Frequently Asked Questions
Do I really need to fan and mist a monotub every day?
A properly dialed-in monotub should not need manual intervention. If you are fanning three times a day, your holes are too small or packed too tight with polyfill. A correctly built system maintains 90%+ humidity through its own metabolic heat and convection for an entire first flush.
What size monotub works best for home growing?
The 54 to 66-quart range. Large enough for 1-2 lbs fresh per flush, small enough to manage even FAE across the surface. Bins above 100 quarts sag under wet substrate weight and create dead-air zones in the corners that stall pinning. For a deeper look at how your tub fits into the bigger picture, see the mushroom cultivation techniques comparison.
Why do people use clear bins instead of opaque?
Mushrooms are phototropic – they use light as a directional signal, not an energy source. Clear bins let ambient room light reach the substrate from all angles so the mushrooms grow straight up toward the top air holes. Opaque bins cause erratic growth patterns and make early contamination nearly invisible.
Can I swap polyfill for Micropore tape?
3M Micropore tape works well. Two layers over the bottom holes, one over the top is a standard starting point. The tradeoff: unlike polyfill, you cannot adjust density on the fly – you add or remove strips of tape instead.
Is it normal for the substrate to pull away from the walls?
Completely normal – and exactly why you need a liner. The mycelium is digesting substrate and transpiring water, so the block loses mass and shrinks. Without a liner clinging to the surface via moisture tension, that gap between block and wall creates a 100% humidity micro-climate that triggers side-pins instead of top-surface fruiting.
Related Articles

Top Mushroom Cultivation Techniques: A Technical Efficiency Comparison
Monotub, Bucket Tek, or PF Tek? A side-by-side comparison using Biological Efficiency and yield per square foot to find the best method for your space.
MEA vs. PDA: The Professional Laboratory Guide to Mushroom Agar Recipes
MEA, PDA, and antibiotic agar — five tested recipes with exact measurements for isolating clean mushroom cultures on plates.

DIY Still Air Box Guide: Engineering a Professional Sterile Lab for Under $20
A $15 plastic tote is the most effective contamination prevention tool in mycology. Here's exactly how to build and use a Still Air Box.